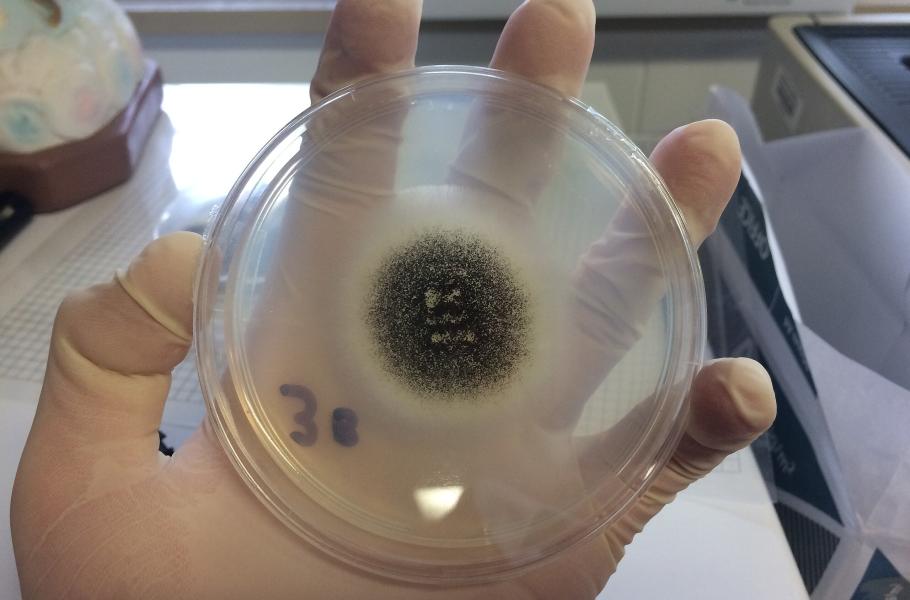

Revoluční antibiotikum z čínského dolu: Funguje jinak než dosud známé léky
Z čínského dolu na vzácné zeminy vzešel nečekaný objev – základ pro nový typ antibiotika, který by mohl porazit i ty nejodolnější bakterie.
Nedaleko severočínského města Pao-tchou ve Vnitřním Mongolsku se nacházejí obrovská naleziště vzácných zemin, která zajišťují podstatnou část světové těžby těchto strategických surovin. Jak se ale ukazuje, zmíněné čínské doly ukrývají i jiná bohatství.
Jaime Felipe Guerrero Garzón z Vídeňské univerzity a jeho kolegové pátrali po slibných látkách, z nichž by se mohla stát nová antibiotika. Soustředili se přitom na aktinomycety (aktinobakterie) – vláknité mikroorganismy, které se nevyhýbají neobvyklým typům prostředí a již nám poskytly antibiotika jako je vankomycin, rifamycin nebo chelokardin.
Antibiotikum z čínského dolu
Nedávno se jim dostal do rukou neobvyklý kmen aktinomycet rodu Amycolatopsis, který pocházel ze zmíněných dolů na vzácné zeminy. Badatelé si všimli, že vykazuje velmi silnou antibakteriální aktivitu. Pomocí hmotnostní spektrometrie a spektroskopie nukleární magnetické rezonance odhalili molekulu, která se na tom do značné míry podílí – doposud neznámý glykopeptid, pojmenovaný saarvienin A.
Ukázalo se, že saarvienin A funguje proti bakteriím ne zcela jasným mechanismem, který se liší od déle známých glykopeptidů antibakteriální povahy, jako je třeba vankomycin. Látka s takovým mechanismem účinku by mohla být účinná proti celé řadě různých bakterií.
První testy saarvieninu A s celou řadou rezistentních bakteriálních patogenů dopadly úspěšně. Nově objevená látka si podle vědců vede lépe než vankomycin. Saarvienin A nyní čekají nezbytné úpravy a vylepšení, které by měly snížit jeho cytotoxicitu při současném zachování antibakteriální aktivity. Ve světle stále rostoucí hrozby antibiotické rezistence přináší objev naději na nový typ antibiotika.